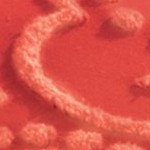
rust

Sponsored



Collections Etc Scalloped Chenille Bedspread
$48.97
In Stock
Eligible for registries and wish lists
Sponsored
About this item
Highlights
- Cotton
- No Assembly Required
- Machine Wash
Description
A Wonderful Way To Add Elegance And Charm To Your Bedroom, This Lovely Chenille Bedspread Features An Exquisite Tufted Medallion And Scroll Diamond Design. Available In Two Beautiful Colors, The Scalloped Edges Provide The Perfect Finishing Touch. Shams Sold Separately. Machine Wash. Cotton; Imported. Choose: Ivory Or Rust. Available In: Full (108" X 96"), Queen (118" X 102") Or King (118" X 118").
Dimensions (Overall): 108 inches (L), 96 inches (W)
Fill Material: 0% No Fill
Fabric Name: Non-Woven Fabric
Textile Material: 100% Cotton
Backing Material: 0% No Backing
Fabric Weight Type: Midweight Fabric
Thread Count: 200
Care and Cleaning: Machine Wash, Drying Instructions Not Provided
TCIN: 1005478082
UPC: 191121766514
Origin: imported
The above item details were provided by the Target Plus™ Partner. Target does not represent or warrant that this information is accurate or complete. On occasion, manufacturers may modify their items and update their labels.
We recommend that you do not rely solely on the information presented. If you have a specific question about this item, you may consult the item's label, contact the manufacturer directly or call Target Guest Services at 1-800-591-3869.
If the item details aren’t accurate or complete, we want to know about it.
Shipping details
Estimated ship dimensions: 20 inches length x 13 inches width x 2.75 inches height
Estimated ship weight: 5.33 pounds
item ships from third party seller: Collections Etc
Return details
This item can be returned to any Target store or Target.com.
This item must be returned within 30 days of the date it was purchased in store, shipped, delivered by a Shipt shopper, or made ready for pickup.
See the return policy for complete information.
Frequently bought together

$12.99 - $13.99
reg $15.99 - $17.99 Sale
5 out of 5 stars with 3 ratings